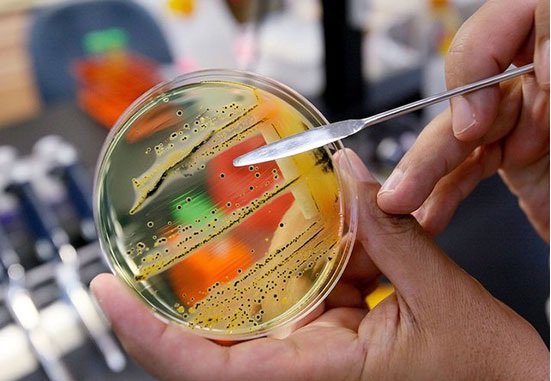

به گزارش خبرنگار ایسنا، از سوی سازمان بینالمللی استاندارد (ISO)، مشخصات فنی TS -13830 در سال 2013 با عنوان «فناوری نانو- دستورالعملی برای برچسب زنی اختیاری محصولات مصرفی شامل نانو اشیاء ساخته شده» منتشر شد. هدف از این دستورالعمل فراهم آوردن چارچوبی برای تسهیل یک روش هماهنگ در زمینه برچسب زنی برای محصولات مصرفی است که حاوی نانو ذرات هستند.
سازمان ISO اشاره میکند که این TS یک دستورالعمل اختیاری برای انتقال اطلاعات خاص محصول است که یک تولید کننده برای اظهار بر روی برچسب محصول انتخاب میکند و این دستورالعمل برای ارائه الزامات اجباری برچسب زنی که توسط نهادهای نظارتی مربوط به هر کشور ایجاد شده، در نظر گرفته نشده است.
این استاندارد و سایر استانداردهای این حوزه در پی نگرانیهایی که در زمینه استفاده از محصولات مبتنی بر نانو بیان شده، تدوین شدند؛ چرا که امروزه شاهد خیل عظیمی از محصولات مبتنی بر نانو از هستیم که صحت و سقم این ادعاها نیاز به روشهای اعتبار سنجی این محصولات دارد. همچنین عمده این نگرانیها مربوط به ایمنی نانو و اثرات این فناوری بر سلامت انسان و محیط زیست میشود.
بر این اساس تدوین استانداردها میتواند در کاهش این نگرانیها نقش موثری داشته باشد و ایران بعد از تایوان دومین کشوری است که موضوع برچسبگذاری و گواهیدهی به محصولات نانو را آغاز کرده است.
در این راستا در اواخر سال 86 همزمان با رشد تولیدات علمی در حوزه نانو فناوری اقدام به ایجاد واحد «بررسی مقیاس مواد و محصولات نانو» در ستاد نانو به منظور بررسی ادعاهای مختلف در این حوزه شد که از آن زمان بررسی محصولات نانو آغاز شده است.
«نانو نماد» یا «نانو مارک» به محصولاتی اعطا میشود که مبتنی بر فناوری نانو باشند و کاربرد این فناوری در محصولات تولید شده به تایید رسیده باشد و همچنین موجب ارتقاء زندگی مردم شود و این نماد برای تک تک محصولات نانویی شرکتهای فعال در این حوزه به مدت 2 سال صادر میشود.
تا پایان مهر ماه سال 88 بیش از 30 تقاضای دریافت نانو مارک به این واحد ارسال شد و پس از انجام آزمونهایی چون اثبات مقیاس نانومتری از طریق آزمونهایی چون SEM ،TEM و آنالیز اندازه ذرات، اثبات افزایش قابل ملاحظه خواص با انجام آزمونهای مقایسهای میان خواص محصولات تولیدی و محصول رایج غیر نانو و اثبات تکرارپذیری فرآیند با ارائه روش تولید اصولی و علمی بر روی موارد ارسال شده، تعداد 13 محصول مبتنی بر فناوری نانو تایید و نانو نماد اعطا شد.
این محصولات شامل مواردی چون «نانو سیال»، «کود کلات آهن خضراء»، «رنگ ضد خش ترافیکی»، «زینک اکساید»، «آمیژه نانو تیتان»، «پلی پروپیلن مقاوم به خراش»، «پلی لاتیس»، «نانو اکسید تیتانیم»، «اسپری زعفران»، «نانو سیلیس»، «نانو جاذب زئولیتی»، «نانو ذرات نقره»، و «نانو کامپوزیت» میشود.
استاندارد سازی گام اول کسب بازارها
دکتر علی بیتاللهی، رییس کمیته استانداردسازی ستاد توسعه فناوری نانو در گفتوگو با خبرنگار ایسنا با تاکید بر اینکه در حال حاضر 60 استاندارد ملی در حوزه نانو فناوری تدوین و منتشر شده است، افزود: از سوی دیگر استانداردهای بینالمللی تدوین کردهایم که در کمیته PC229 ایزو برای تصویب عرضه کردهایم.
وی با بیان اینکه تدوین این استانداردها بر اساس نیاز محصولات و دانشهای توسعه یافته مبتنی بر نانو فناوری بوده است، اضافه کرد: در حال حاضر یکی از محصولاتی که با استفاده از فناوری نانو توسعه یافته، نانو الیاف مورد استفاده در فیلترهای نانویی است که استاندارد آن تدوین و به کمیته PC229 ایزو پیشنهاد شده است.
بیت اللهی از تصویب این استاندارد در این کمیته خبر داد و یادآور شد: بر این اساس ایران به عنوان تدوین کننده استاندارد بین المللی فیلترهای نانویی تعیین شده است.
تدوین دو استاندارد دیگر در زمینه نانو
رییس کمیته استانداردسازی ستاد توسعه فناوری نانو تدوین استاندارد در حوزه نانو رس (Nano clay) را از دیگر زمینههای فعالیت کمیته استاندارد سازی نام برد و خاطرنشان کرد: علاوه بر آن استاندارد دیگری در زمینه بسته بندیهای کامپوزیتی در دستور کار داریم.
بیت اللهی، ویژگی این بسته بندی را در افزایش ماندگاری و طول عمر محصولات غذایی و کشاورزی دانست و اظهار کرد: این استاندارد اخیرا در کمیته PC229 ایزو مورد تصویب قرار گرفته است و مراحل اجرایی خود را میگذراند.
برنامههای آتی ستاد نانو
رییس کمیته روابط بین الملل ستاد توسعه فناوری نانو با اشاره به برنامههای این کمیته خاطر نشان کرد: درصددهستیم که تا 5 سال آینده حداقل 10 استاندارد بین المللی را به کمیته استاندارد PC229 ایزو ارائه دهیم.
وی اضافه کرد: علاوه بر آن بر اساس برنامهریزیهای صورت گرفته قرار است تا 10 سال آینده بیش از 200 استاندارد ملی را تدوین کنیم.
بیتاللهی هدف از این اقدام را پشتیبانی از محصولات تولید شده مبتنی بر فناوری نانو در کشور و حمایت از محصولات داخلی در بازارهای جهانی عنوان کرد.
رییس کمیته استاندارد سازی ستاد توسعه فناوری نانو تاکید کرد: طبیعی است که وقتی شرکتهای داخلی در استانداردهای بینالمللی مشارکت داشته باشند در بازارهای ملی و بینالمللی مورد توجه قرار خواهند گرفت.
بیت اللهی با تاکید بر اینکه کمیته استاندارد سازی برنامههای گستردهای در زمینه استاندارد نانو فناوری دارد، گفت: با اقداماتی که تاکنون اجرایی شده، ایران به عنوان یکی از کشورهای فعال در عرصه تدوین استانداردهای ملی و بین المللی در دنیا شناخته شده است به گونهای که تاکنون 5 دوره از جمهوری اسلامی ایران به دلیل نقش آفرینی در تدوین استانداردهای ملی و بینالمللی در کمیته PC229 تقدیر شده است.
نانو نماد پس از 8 سال تلاش
رییس کمیته استاندارد سازی ستاد توسعه فناوری نانو در خصوص سرنوشت اعطای نانو نماد و کشمکشهای ستاد نانو با سازمان استاندارد در زمینه اعطای این نماد، خبر از موافقت شورای عالی استاندارد با اعطای نانو نماد داد.
وی خاطر نشان کرد: با این موافقت ما منتظر هستیم تا اولین جلسه مشترک سازمان ملی استاندارد با ستاد نانو برگزار شود تا بتوانیم کمیته اجرایی مرتبط با اعطای این نماد را تشکیل دهیم.
بیت اللهی ابراز امیدواری کرد که این نماد در سطح ملی به محصولات تولید شده مبتنی بر نانو اعطا شود و ادامه داد: اعطای نانو نماد در راستای حمایت از بازار و همچنین اعتماد سازی برای مشتریان خواهد بود.
وی با تاکید بر اینکه ایران اولین کشور دنیا است که در سطح ملی پذیرفته است که چنین نمادی را به محصولات مبتنی بر نانو اعطا کند، افزود: ما برای رسیدن به این جایگاه به مدت 8 سال مقدمات آن را که شامل برنامه ریزی، طراحی و نحوه اجرا و پیاده سازی میشود، فراهم کردیم که خوشبختانه سازمان ملی استاندارد از آن پشتیبانی و آن را در شورای عالی استاندارد که عالیترین مقام تصویب چنین برنامههای است، به تصویب رساند.
عضو هیات علمی دانشگاه علم و صنعت، از اقدامات ستاد نانو برای اعطای نانو نماد در سال جاری خبر داد و گفت: اعطای این نماد در سطح ملی افتخاری برای کشور است؛ چراکه ایران در میان کشورهای فعال در دنیا قرار گرفته است که در چارچوبهای مشخص و معینی برای اعطای این نماد به محصولات نانویی تعیین کرده است.
بیتاللهی توسعه بازارهای ملی و بین المللی را از مزایای اعطای این نماد ذکر کرد.
اعتبار نانو نماد ملی
رییس کمیته استاندارد سازی ستاد فناوری نانو با تاکید بر اینکه نانو نماد ملی تنها در کشور اعتبار دارد، گفت: اعطای نانو نماد به محصولات مبتنی بر نانو فناوری یک موضوع جدید است و ایران نیز از 6 سال قبل در این زمینه اقدام کردیم.
وی ادامه داد: بر این اساس به شرکتهای فعال در حوزه نانو فناوری که برای دریافت تسهیلات ستاد به ما مراجعه میکردند اقدام به اعطای «نانو مقیاس» کردیم و در حال حاضر این امکان وجود دارد که این نماد با عنوان «نانو نماد» در سطح ملی و با همکاری سازمان ملی استاندارد اعطا شود.
بیتاللهی خاطر نشان کرد: این نماد بیان کننده چارچوبهایی است که به مشتریان اطمینان لازم را میدهد.
وی تعیین اندازه نانو ذرات به کار رفته در محصول را از جمله شاخصهای ارزیابی محصولات برای دریافت نانو دانست و اظهار کرد: علاوه بر آن شاخصهای دیگری چون ارتقای کیفی محصولات، ایمنی و قابلیت تکرار محصول مورد ارزیابی قرار خواهد گرفت.
بیت اللهی یادآور شد: برای ارزیابی هر کدام از شاخصها ریز ساختهایی را از جمله آزمایشگاهها را ایجاد کردیم تا ارزیابیهای لازم برای اعطای نانو نماد صورت گیرد.
به گفته رییس کمیته استانداردسازی ستاد توسعه فناوری نانو، این نماد از سوی ستاد توسعه فناوری نانو و با همکاری سازمان ملی استاندارد و وزارتخانههایی چون بهداشت، درمان و آموزش پزشکی و جهاد کشاورزی اعطا میشود.
تلاش برای صدور نماد مشترک آسیایی در حوزه نانو
رییس کمیته استاندارد سازی ستاد نانو از برنامههای این ستاد از اجرای یک برنامه مشترک در حوزه نانو نماد خبر داد و در این باره گفت: در این برنامه در تلاش هستیم تا نانو نماد به عنوان یک برنامه مشترک با برخی از کشورها اجرایی شود.
وی افزود: بر این اساس تاکنون با کشور روسیه توافقنامهای را در زمینه اعطای نانو نماد مشترک به امضا رساندیم.
رییس کمیته روابط بین الملل ستاد توسعه فناوری نانو با اشاره به مذاکرات انجام شده با کشورهای آسیایی چون کره، تایوان، تایلند و مالزی،گفت: این مذاکرات برای طراحی نانو نماد آسیایی بوده است.
بیت اللهی در پایان خاطر نشان کرد: طراحی یک نانو نماد آسیایی یک برنامه زمانبر و دراز مدت است ولی زمینه سازیهای اولیه آن انجام شده است ولی ما نشستی را سال قبل در تهران و با حضور 6 کشور آسیایی با موضوع «نانو نماد آسیایی» برگزار کردیم و امیدوارم با پیگیری این موضوع در آینده بتوانیم به این نماد مشترک برسیم.
انتهای پیام